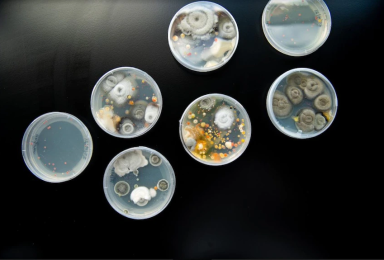

Healing the planet and making money aren’t mutually exclusive.

Panthalassa’s Ocean-2
The teams we back are building unreasonably ambitious solutions to cut emissions and suck up carbon, all while getting paid.
Making solar and wind work 24/7.
Antora

Unlocking the clean economy's trillions.
Crux

Emissions-slashing compute clusters.
Crusoe

Plug into the ocean.
Panthalassa

Plasma-taming fusion magnets.
Commonwealth Fusion Systems

Solarizing Indian rooftops.
Solar Square

Making chemicals with enzymes, not oil.
Solugen

Fully-electric passenger planes.
Heart

Squeezing more juice from batteries.
Breathe

Zero-carbon cement.
Sublime

Pumping oil back into the ground.
Charm

Turning exhaust emissions into revenue streams.
Remora

Clean, fast, cheap lithium mining.
Lilac

Food waste magic.
Mill

Freight trucking goes electric.
Nevoya

Planet-friendly fertilizer farmers love.
Kula

Space-based power stations.
Overview

100% beef that never had eyes nor hooves.
Mosa

Ultra-powerful electric boats.
Arc

The grid’s battery buildout.
Base Power

Iceberg-saving cold chain.
Artyc

Your grid’s fire alarm.
Gridware

Plugging Brazil into the sun.
Lemon

Property insurance for climate chaos.
Stand

Own your energy.
Fuse

Taming the stellarator with software.
Thea Energy

The cleanest way to space.
Astro Mechanica

Giant carbon-sucking vacuums.
Carbon Engineering

Waste disposal that trashes CO₂
Vaulted

Wind power on a clothesline.
Airloom

Literally paving the way to net-zero.
Carbon Crusher

Batteries that mine lithium.
Lithios

Turning CO2 into jet fuel.
Twelve

Zero-waste fashion.
Unspun

A rocket engine to boost the grid.
Arbor

Europe's solar financing on-switch.
Cloover

Fertilizer out of thin air.
Nitricity

The API that wrangles IRA dollars.
Eli

Supercharged pulse fusion.
Pacific Fusion

Fusion from frickin' laser beams.
Xcimer

Fusion without the fuss.
Renaissance

Farming flies for feed.
Entocycle

Battery waste reincarnated.
Aepnus

Plasma-free fusion.
Acceleron

Trashing Brazil’s waste problem.
Musa

Juicing up the e-moto wave.
Zeno

Making heat pumps cool.
Quilt

Fighting wildfires before they start.
BurnBot

Biotech at a planetary scale.
Biosphere

Ocean rewilding with a robot assist.
Ulysses

Wood with muscles of steel.
Woodoo

Commercial batteries that practically store cash.
Storio

CO₂ reborn.
Dioxycle

Freight-friendly carbon offsets.
Pledge

Self improving supply chains.
Pendulum

Mean, green, biological machines.
General Biological

Universal API for EV charging.
Enode

India's practical, badass e-moto.
River

Compute power from clean energy leftovers.
Rune Energy

Decarbonizing shipping.
Seabound

Capturing carbon with carbon.
Noya

DAC faster than you can say DAC.
Carbyon

Forest-planting drones.
Dendra

Super-cheap green hydrogen.
Supercritical

Mapping Earth's materials.
Matter

CRISPR for metals.
Milvus Advanced

Farm-to-bank carbon removal.
Loam
Looks like meat, tastes like meat.
Tender

Taking the waste out of recycling.
Safi

Cheap fusion power. Seriously.
Zap

Fast-tracking sustainable jet fuel.
Air Co

Go solar. Get paid.
Lumen

When carbon and rocks become one.
Heirloom

Rocking carbon, renewing soil.
Undo

Clean kitesurfing cargo ships.
CargoKite

Turn mine waste into climate gold.
Arca

Suck up carbon, not energy.
Verdox

CDR standards that set the standard.
Isometric

Hard rock, easy lithium.
Novalith

Big magma energy.
Zanskar

Carbon-guzzling supertrees.
Living Carbon

DAC that sucks carbon, not cash.
Clairity

Energy autopilot for your HVAC.
Flair

Growing the rooftop solar grid.
InRange

Kelp as the new corn.
Macro Oceans

Methane bounty hunters.
Frost Methane

Cooking oil that doesn’t fry the planet.
Zero Acre

Carbon rehab for your business.
Watershed

AI life raft for flood insurance.
Floodbase

AI for fire reinsurance.
Kettle

Handheld fusion reactors.
Avalanche

Steel from the sun.
Electra

Plastic-eating enzymes.
Epoch

Restore nature. Remove carbon.
Pachama

Coffee minus coffee.
Minus

Real dairy sans cows.
Formo

Cleaning up Africa’s cookstoves.
Ecosafi

Robots saving water and farms.
FarmHQ

Measure soil carbon in a snap.
Yard Stick

Plants that mine metals.
Genomines

Loose lips sink ships.
Stealth


